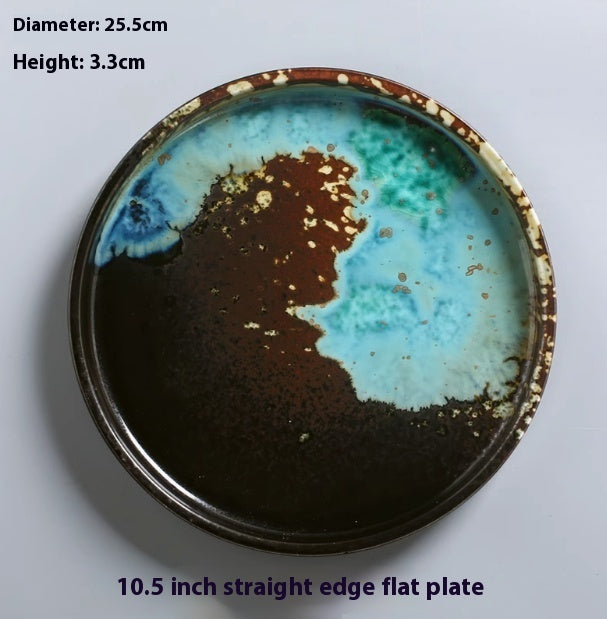
Handmade Japanese Tableware Handmade Plates

Products
-
304 Stainless Steel Peeling Knife Melon Planer Multi-Function Peeler Grater Vegetable And Fruit Scraping Knife Kitchen Tools 





304 Stainless Steel Peeling Knife Melon Planer Multi-Function Peeler Grater Vegetable And Fruit Scraping Knife Kitchen Tools
R 156.40 ZAR304 Stainless Steel Peeling Knife Melon Planer Multi-Function Peeler Grater Vegetable And Fruit Scraping Knife Kitchen Tools
R 156.40 ZAR -
Cling Film Suction Cup Wall-mounted Box Kitchen Adjustable Storage Cutter 





Cling Film Suction Cup Wall-mounted Box Kitchen Adjustable Storage Cutter
R 394.00 ZARCling Film Suction Cup Wall-mounted Box Kitchen Adjustable Storage Cutter
R 394.00 ZAR -
Coffee cup set 




Coffee cup set
R 449.80 ZARCoffee cup set
R 449.80 ZAR -
Electric Cooking Pot Dormitory Small Cooking Pot 





Electric Cooking Pot Dormitory Small Cooking Pot
R 1,061.40 ZARElectric Cooking Pot Dormitory Small Cooking Pot
R 1,061.40 ZAR -
Electric heater 360 rotating plug mini heater small appliances 






Electric heater 360 rotating plug mini heater small appliances
R 388.00 ZARElectric heater 360 rotating plug mini heater small appliances
R 388.00 ZAR -
Electric Kitchen Household Grinder 







Electric Kitchen Household Grinder
R 260.00 ZARElectric Kitchen Household Grinder
R 260.00 ZAR -
Fast Defrost Tray Fast Thaw Frozen Food Meat Fruit Quick Defrosting Plate Board Defrost Tray Thaw Master Kitchen Gadgets 







Fast Defrost Tray Fast Thaw Frozen Food Meat Fruit Quick Defrosting Plate Board Defrost Tray Thaw Master Kitchen Gadgets
R 239.60 ZARFast Defrost Tray Fast Thaw Frozen Food Meat Fruit Quick Defrosting Plate Board Defrost Tray Thaw Master Kitchen Gadgets
R 239.60 ZAR -
Fully Automatic Mixing Cup Fried Juice Cup Milkshake Cup 







Fully Automatic Mixing Cup Fried Juice Cup Milkshake Cup
R 633.20 ZARFully Automatic Mixing Cup Fried Juice Cup Milkshake Cup
R 633.20 ZAR -
Gold Dinnerware Set Stainless Steel Tableware Set Knife Fork Spoon Luxury Cutlery Set With Storage Rack Dishwasher 









Gold Dinnerware Set Stainless Steel Tableware Set Knife Fork Spoon Luxury Cutlery Set With Storage Rack Dishwasher
R 891.60 ZARGold Dinnerware Set Stainless Steel Tableware Set Knife Fork Spoon Luxury Cutlery Set With Storage Rack Dishwasher
R 891.60 ZAR -
Handheld High-Power Vacuum Cleaner For Small Cars 









Handheld High-Power Vacuum Cleaner For Small Cars
R 376.00 ZARHandheld High-Power Vacuum Cleaner For Small Cars
R 376.00 ZAR -
Handmade Japanese Tableware Handmade Plates 















Handmade Japanese Tableware Handmade Plates
R 390.00 ZARHandmade Japanese Tableware Handmade Plates
R 390.00 ZAR -
Home Automatic Stainless Steel Electric Hot And Cold Milk Whipping Machine Kitchen Gadgets 






Home Automatic Stainless Steel Electric Hot And Cold Milk Whipping Machine Kitchen Gadgets
R 825.20 ZARHome Automatic Stainless Steel Electric Hot And Cold Milk Whipping Machine Kitchen Gadgets
R 825.20 ZAR -
Home mosquito killer artifact 





Home mosquito killer artifact
R 256.80 ZARHome mosquito killer artifact
R 256.80 ZAR -
Hook sponge storage rack 







Hook sponge storage rack
R 95.60 ZARHook sponge storage rack
R 95.60 ZAR -
Household Breakfast Machine Hamburg Sandwich Maker With Egg Cooker Ring Machine Bread Sandwich Machine Waffle Machine 








Household Breakfast Machine Hamburg Sandwich Maker With Egg Cooker Ring Machine Bread Sandwich Machine Waffle Machine
R 967.60 ZARHousehold Breakfast Machine Hamburg Sandwich Maker With Egg Cooker Ring Machine Bread Sandwich Machine Waffle Machine
R 967.60 ZAR -
Household Dinner Plate, Flat Plate, Bowl And Plate Set 






Household Dinner Plate, Flat Plate, Bowl And Plate Set
R 490.80 ZARHousehold Dinner Plate, Flat Plate, Bowl And Plate Set
R 490.80 ZAR -
Kitchen Folding Storage Rack with Draining Basket Fruit Vegetable Storage Holder Stackable Shelf Space Saving Organizer 




Kitchen Folding Storage Rack with Draining Basket Fruit Vegetable Storage Holder Stackable Shelf Space Saving Organizer
R 349.80 ZARKitchen Folding Storage Rack with Draining Basket Fruit Vegetable Storage Holder Stackable Shelf Space Saving Organizer
R 349.80 ZAR -
Kitchen Household Peeler Gadget Copper Plating Set 











Kitchen Household Peeler Gadget Copper Plating Set
R 580.00 ZARKitchen Household Peeler Gadget Copper Plating Set
R 580.00 ZAR -
Kitchen sink drain bag 







Kitchen sink drain bag
R 130.00 ZARKitchen sink drain bag
R 130.00 ZAR -
Milk frother, milk electric heater 




Milk frother, milk electric heater
R 931.80 ZARMilk frother, milk electric heater
R 931.80 ZAR -
Mini Fan Heater Wall-mounted Dormitory Warm Artifact 









Mini Fan Heater Wall-mounted Dormitory Warm Artifact
R 330.80 ZARMini Fan Heater Wall-mounted Dormitory Warm Artifact
R 330.80 ZAR -
Mini Portable Handheld Garment Steamer Fabric Steam Iron For Clothes Travel Home Appliances Vertical US Plug Ironing Machine 










Mini Portable Handheld Garment Steamer Fabric Steam Iron For Clothes Travel Home Appliances Vertical US Plug Ironing Machine
R 278.00 ZARMini Portable Handheld Garment Steamer Fabric Steam Iron For Clothes Travel Home Appliances Vertical US Plug Ironing Machine
R 278.00 ZAR -
Multi-function lunch box 







Multi-function lunch box
R 556.20 ZARMulti-function lunch box
R 556.20 ZAR -
Multifunctional Egg Cooker Mini Egg Steamer Breakfast Egg Steamer 





Multifunctional Egg Cooker Mini Egg Steamer Breakfast Egg Steamer
R 565.80 ZARMultifunctional Egg Cooker Mini Egg Steamer Breakfast Egg Steamer
R 565.80 ZAR